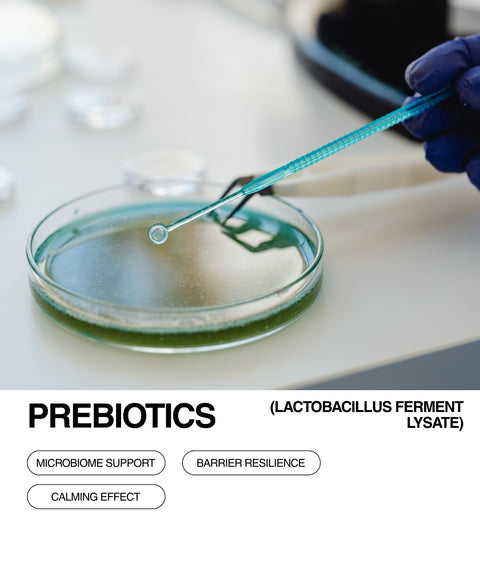
A gloved hand holds a pipette above a petri dish with green liquid. Text below reads Prebiotics (Lactobacillus Ferment Lysate) with phrases: Microbiome Support, Barrier Resilience, and Calming Effect.

MORE INFORMATION:
PRODUCT VOLUME/WEIGHT:
INGREDIENTS/INCL:
STAR FEATURES:
CONCERN ADDRESSED:
SKIN TYPE:
AROMA:
STAR INGREDIENTS
THE UNNATURAL SKIN CARE INGREDIENTS CURRENTLY USED BY THE SKINCARE INDUSTRY ARE SILENTLY HURTING YOU.
WE COMMIT TO ALL NATURAL/ORGANIC INGREDIENTS AND FORMULATIONS THAT STILL PROVIDE RESULTS. NO TRADE-OFFS. SKINCARE CAN USE CLEAN INGREDIENTS & STILL BE EFFECTIVE.
CLARITY IS KEY AT RESÖ; SO YOU CAN MAINTAIN YOUR HEALTH INSIDE AND OUT.
OUR COMMITMENT TO CLEAN SKINCARE